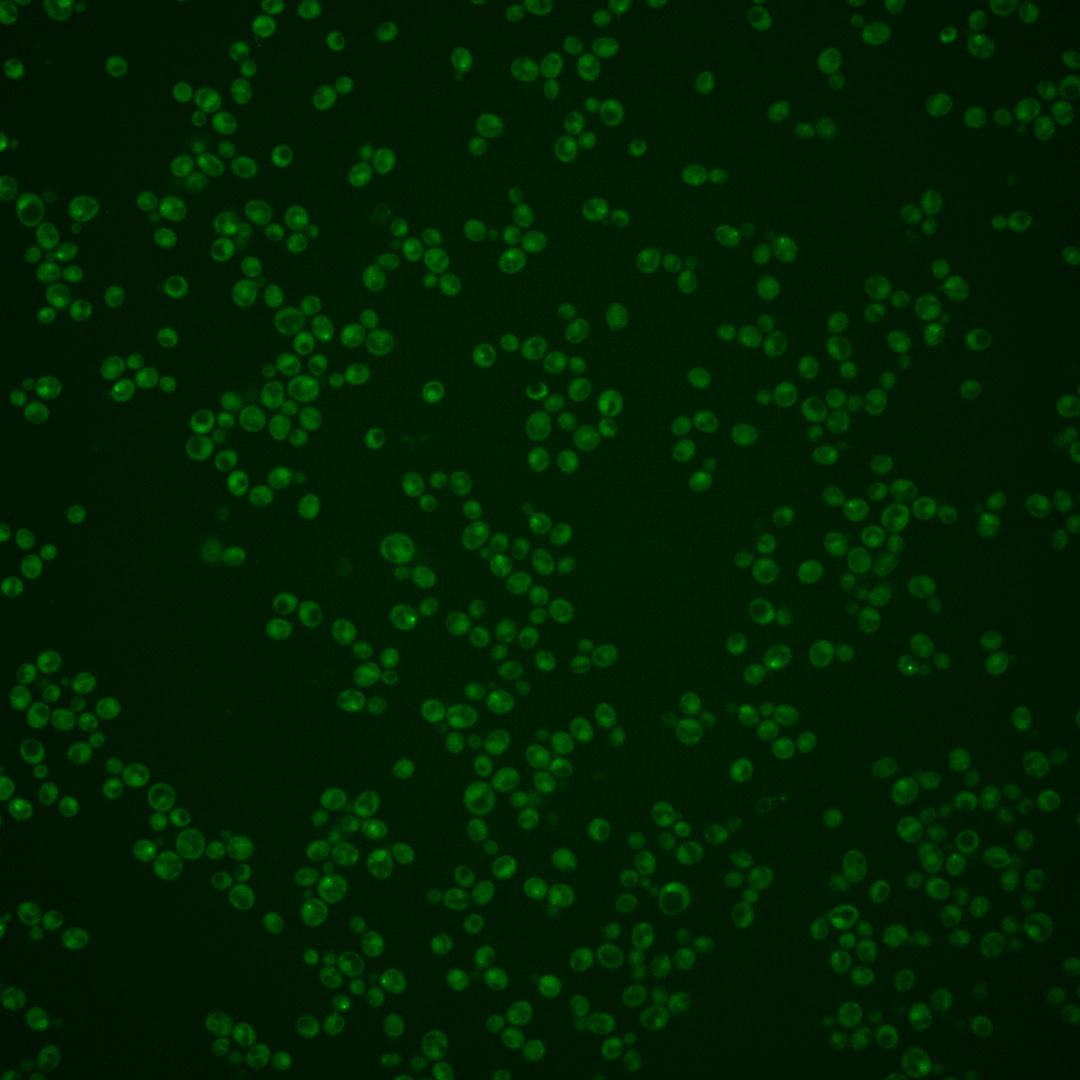
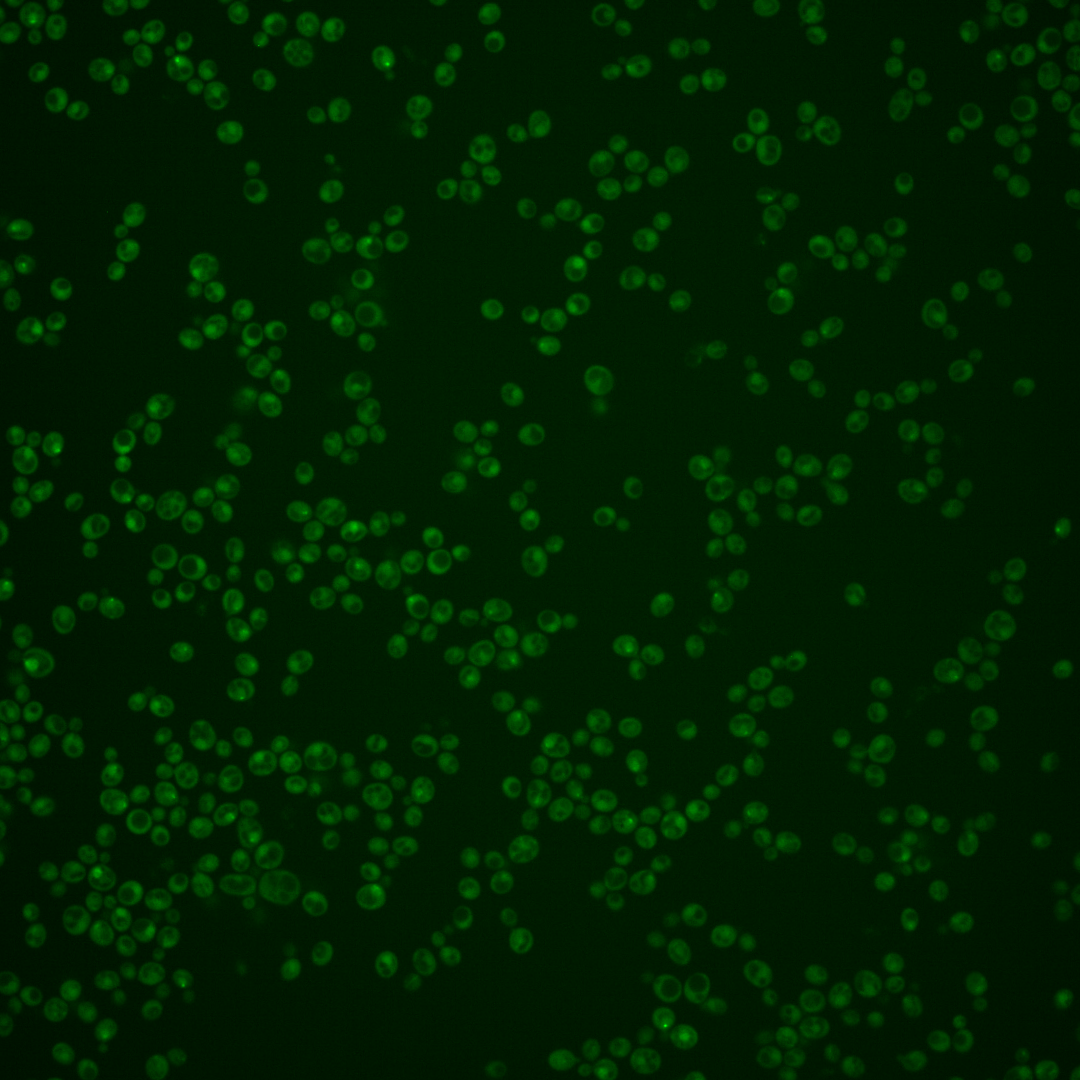
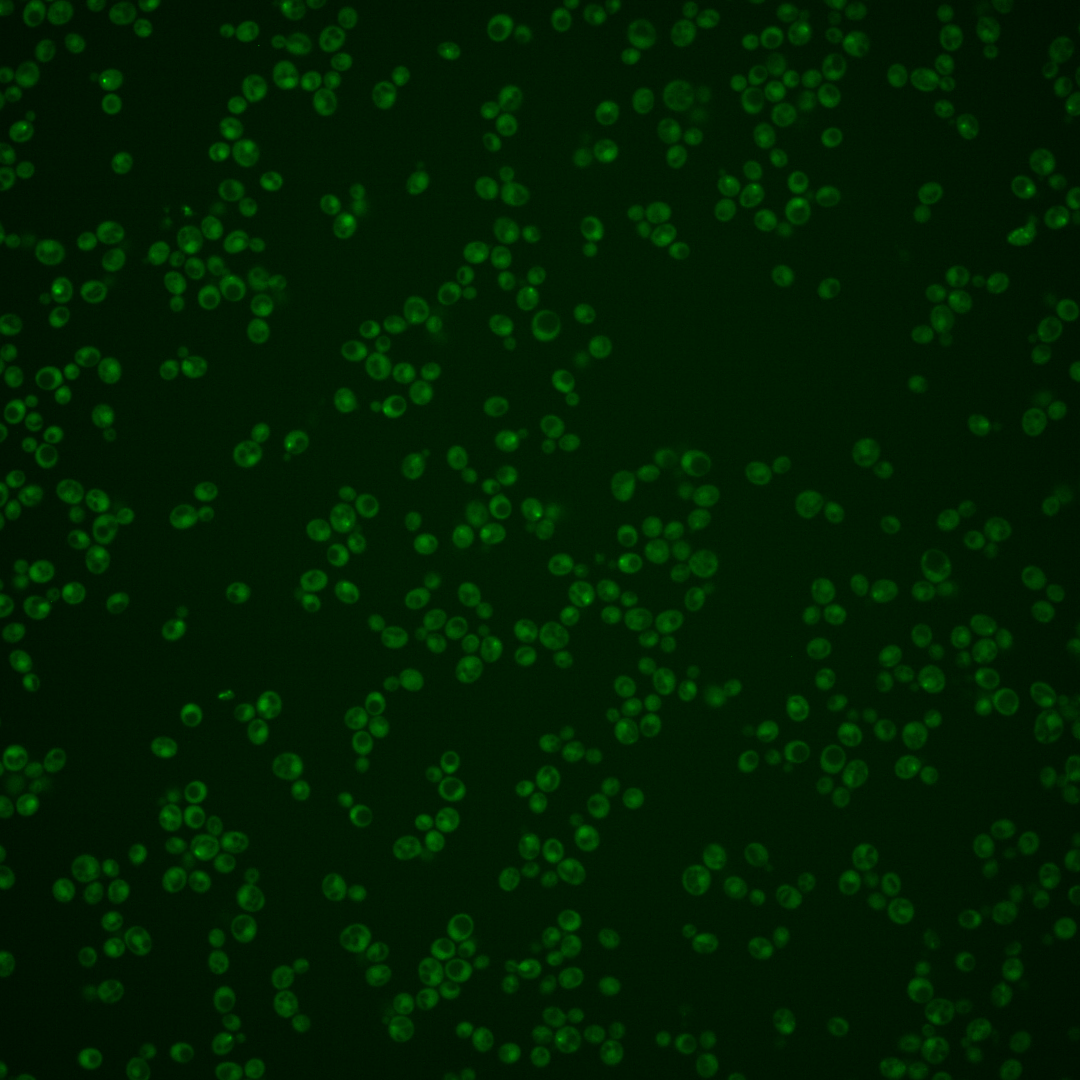

| Standard name | |
|---|---|
| Human Ortholog | |
| Description | Component of the spindle checkpoint; involved in sensing lack of tension on mitotic chromosomes; protects centromeric Rec8p at meiosis I; required for accurate chromosomal segregation at meiosis II and for mitotic chromosome stability; recruits condensin to the pericentric region of chromosomes during meiosis; dissociates from pericentromeres when sister kinetochores are under tension |
Micrographs




















































































Sub-cellular Localization
Yeast GFP Assignment
Protein Abundance
Localization Change
External localization resources
| ensLOC | DeepLoc | |||||||||||||||||||||||
|---|---|---|---|---|---|---|---|---|---|---|---|---|---|---|---|---|---|---|---|---|---|---|---|---|
| Localization | WT1 | WT2 | WT3 | RAP60 | RAP140 | RAP220 | RAP300 | RAP380 | RAP460 | RAP540 | RAP620 | RAP700 | HU80 | HU120 | HU160 | rpd3Δ_1 | rpd3Δ_2 | rpd3Δ_3 | WT1 | WT2 | WT3 | AF100 | AF140 | AF180 |
| Cortical Patches | 0 | 0 | 0 | 0 | 0 | 1 | 0 | – | 0 | 1 | 0 | 0 | – | – | – | 1 | 0 | 0 | 0 | 2 | 0 | 0 | 0 | 0 |
| Bud | 0 | 0 | 0 | 0 | 2 | 0 | 2 | – | 3 | 2 | 3 | 6 | – | – | – | 0 | 0 | 1 | 0 | 6 | 1 | 0 | 0 | 1 |
| Bud Neck | 1 | 2 | 0 | 6 | 18 | 9 | 11 | – | 6 | 12 | 5 | 8 | – | – | – | 2 | 2 | 2 | 0 | 2 | 0 | 0 | 0 | 0 |
| Bud Site | 0 | 0 | 0 | 0 | 0 | 0 | 0 | – | 0 | 1 | 0 | 1 | – | – | – | 0 | 0 | 0 | – | – | – | – | – | – |
| Cell Periphery | 0 | 0 | 0 | 1 | 0 | 0 | 1 | – | 2 | 1 | 0 | 1 | – | – | – | 2 | 1 | 2 | 0 | 0 | 0 | 0 | 0 | 0 |
| Cytoplasm | 79 | 134 | 31 | 95 | 155 | 158 | 166 | – | 112 | 141 | 74 | 102 | – | – | – | 151 | 115 | 138 | 52 | 109 | 23 | 1 | 13 | 38 |
| Endoplasmic Reticulum | 2 | 0 | 0 | 1 | 2 | 0 | 0 | – | 0 | 0 | 0 | 1 | – | – | – | 17 | 11 | 14 | 0 | 0 | 1 | 0 | 0 | 0 |
| Endosome | 3 | 11 | 1 | 2 | 6 | 5 | 0 | – | 2 | 1 | 1 | 2 | – | – | – | 23 | 22 | 19 | 2 | 6 | 1 | 0 | 0 | 0 |
| Golgi | 0 | 0 | 0 | 0 | 0 | 0 | 0 | – | 0 | 0 | 0 | 0 | – | – | – | 0 | 2 | 1 | 0 | 0 | 0 | 0 | 0 | 0 |
| Mitochondria | 18 | 1 | 1 | 2 | 1 | 6 | 15 | – | 47 | 38 | 76 | 61 | – | – | – | 6 | 3 | 8 | 16 | 6 | 9 | 0 | 0 | 1 |
| Nucleus | 0 | 4 | 0 | 2 | 5 | 1 | 6 | – | 5 | 4 | 3 | 5 | – | – | – | 7 | 2 | 4 | 0 | 5 | 0 | 0 | 0 | 0 |
| Nuclear Periphery | 0 | 0 | 0 | 0 | 0 | 0 | 0 | – | 0 | 0 | 0 | 0 | – | – | – | 0 | 0 | 0 | 1 | 0 | 0 | 0 | 0 | 0 |
| Nucleolus | 0 | 0 | 0 | 0 | 0 | 0 | 0 | – | 3 | 1 | 1 | 1 | – | – | – | 5 | 9 | 1 | 0 | 4 | 0 | 0 | 0 | 0 |
| Peroxisomes | 0 | 1 | 0 | 0 | 0 | 1 | 0 | – | 0 | 0 | 0 | 0 | – | – | – | 1 | 2 | 0 | 0 | 0 | 0 | 0 | 0 | 0 |
| SpindlePole | 6 | 14 | 6 | 21 | 58 | 27 | 29 | – | 18 | 29 | 9 | 13 | – | – | – | 36 | 28 | 22 | 26 | 39 | 18 | 2 | 0 | 2 |
| Vac/Vac Membrane | 1 | 3 | 1 | 0 | 4 | 2 | 0 | – | 2 | 3 | 4 | 2 | – | – | – | 9 | 13 | 12 | 5 | 3 | 2 | 0 | 0 | 0 |
| Unique Cell Count | 102 | 164 | 39 | 122 | 232 | 196 | 210 | 167 | 200 | 143 | 162 | 216 | 174 | 191 | 113 | 191 | 63 | 5 | 17 | 49 | ||||
| Labelled Cell Count | 110 | 170 | 40 | 130 | 251 | 210 | 230 | 200 | 234 | 176 | 203 | 260 | 210 | 224 | 113 | 191 | 63 | 5 | 17 | 49 | ||||
Yeast GFP Assignment
Protein Abundance
| Screen | WT1 | WT2 | WT3 | RAP60 | RAP140 | RAP220 | RAP300 | RAP380 | RAP460 | RAP540 | RAP620 | RAP700 | HU80 | HU120 | HU160 | rpd3Δ_1 | rpd3Δ_2 | rpd3Δ_3 | AF100 | AF140 | AF180 |
|---|---|---|---|---|---|---|---|---|---|---|---|---|---|---|---|---|---|---|---|---|---|
| Mean Cell GFP Intensity (1e-4) | 3.3 | 4.3 | 4.6 | 4.5 | 5.1 | 4.2 | 4.1 | – | 3.5 | 3.7 | 3.2 | 3.6 | – | – | – | 5.7 | 5.7 | 5.3 | – | – | 4.6 |
| Std Deviation (1e-4) | 0.4 | 1.1 | 0.6 | 1.2 | 1.6 | 1.4 | 1.5 | – | 1.2 | 1.3 | 1.0 | 1.3 | – | – | – | 1.3 | 1.4 | 1.2 | – | – | 1.5 |
| Intensity Change (Log2) | – | – | – | -0.02 | 0.16 | -0.13 | -0.15 | – | -0.39 | -0.31 | -0.5 | -0.34 | – | – | – | 0.33 | 0.32 | 0.22 | – | – | 0.02 |
Localization Change
| Localization | RAP60 | RAP140 | RAP220 | RAP300 | RAP380 | RAP460 | RAP540 | RAP620 | RAP700 | HU80 | HU120 | HU160 | rpd3Δ_1 | rpd3Δ_2 | rpd3Δ_3 |
|---|---|---|---|---|---|---|---|---|---|---|---|---|---|---|---|
| Actin | – | – | – | – | – | – | – | – | – | – | – | – | – | – | – |
| Bud | – | – | – | – | – | – | – | – | – | – | – | – | – | – | – |
| Bud Neck | – | – | – | – | – | – | – | – | – | – | – | – | – | – | – |
| Bud Site | – | – | – | – | – | – | – | – | – | – | – | – | – | – | – |
| Cell Periphery | – | – | – | – | – | – | – | – | – | – | – | – | – | – | – |
| Cyto | – | – | – | – | – | – | – | – | – | – | – | – | – | – | – |
| Endoplasmic Reticulum | – | – | – | – | – | – | – | – | – | – | – | – | – | – | – |
| Endosome | – | – | – | – | – | – | – | – | – | – | – | – | – | – | – |
| Golgi | – | – | – | – | – | – | – | – | – | – | – | – | – | – | – |
| Mitochondria | – | – | – | – | – | – | – | – | – | – | – | – | – | – | – |
| Nuclear Periphery | – | – | – | – | – | – | – | – | – | – | – | – | – | – | – |
| Nuc | – | – | – | – | – | – | – | – | – | – | – | – | – | – | – |
| Nucleolus | – | – | – | – | – | – | – | – | – | – | – | – | – | – | – |
| Peroxisomes | – | – | – | – | – | – | – | – | – | – | – | – | – | – | – |
| SpindlePole | – | – | – | – | – | – | – | – | – | – | – | – | – | – | – |
| Vac | – | – | – | – | – | – | – | – | – | – | – | – | – | – | – |
| Cortical Patches | – | – | – | – | – | – | – | – | – | – | – | – | – | – | – |
| Cytoplasm | – | – | – | – | – | – | – | – | – | – | – | – | – | – | – |
| Nucleus | – | – | – | – | – | – | – | – | – | – | – | – | – | – | – |
| Vacuole | – | – | – | – | – | – | – | – | – | – | – | – | – | – | – |
External localization resources
Images






























Protein Concentration and Protein Localization Data
| R1 | R2 | R3 | ||||||||||||||||
|---|---|---|---|---|---|---|---|---|---|---|---|---|---|---|---|---|---|---|
| G1 Pre-START | G1 Post-START | S/G2 | Metaphase | Anaphase | Telophase | G1 Pre-START | G1 Post-START | S/G2 | Metaphase | Anaphase | Telophase | G1 Pre-START | G1 Post-START | S/G2 | Metaphase | Anaphase | Telophase | |
| Concentration | -0.9173 | -0.7708 | -0.4192 | -0.4671 | -0.3494 | -0.5899 | -0.3945 | -0.3386 | -0.1742 | 0.2532 | -0.0316 | -0.6615 | -1.3692 | -1.1862 | -1.0037 | -0.4135 | -0.5162 | -1.2702 |
| Actin | 0.0221 | 0.0033 | 0.0098 | 0.0016 | 0.0036 | 0.0097 | 0.024 | 0.0004 | 0.0015 | 0.056 | 0.029 | 0.0026 | 0.0294 | 0.002 | 0.0148 | 0.12 | 0.026 | 0.0047 |
| Bud | 0.0018 | 0.0032 | 0.0058 | 0 | 0.0004 | 0.003 | 0.0008 | 0.0004 | 0.0005 | 0.0002 | 0.0027 | 0.0001 | 0.0036 | 0.0113 | 0.0004 | 0.0012 | 0.0013 | 0 |
| Bud Neck | 0.0062 | 0.0037 | 0.0094 | 0.0006 | 0.0006 | 0.0034 | 0.0074 | 0.0008 | 0.001 | 0.0042 | 0.0014 | 0.001 | 0.0014 | 0.0011 | 0.0012 | 0.0047 | 0.0025 | 0.0003 |
| Bud Periphery | 0.0035 | 0.0012 | 0.0059 | 0.0001 | 0.0008 | 0.0041 | 0.0015 | 0.0004 | 0.0019 | 0.0003 | 0.0142 | 0.0003 | 0.0012 | 0.0032 | 0.0004 | 0.0018 | 0.0035 | 0.0001 |
| Bud Site | 0.0153 | 0.005 | 0.0047 | 0.0001 | 0.0012 | 0.0011 | 0.014 | 0.0076 | 0.002 | 0.0011 | 0.0045 | 0.0003 | 0.003 | 0.0128 | 0.0019 | 0.0061 | 0.0016 | 0 |
| Cell Periphery | 0.0006 | 0.0002 | 0.0002 | 0 | 0.0002 | 0.0002 | 0.0007 | 0.0001 | 0.0002 | 0.0002 | 0.0006 | 0.0001 | 0.0003 | 0.0006 | 0.0001 | 0.0003 | 0.0003 | 0 |
| Cytoplasm | 0.0292 | 0.031 | 0.0368 | 0.0482 | 0.0269 | 0.0455 | 0.0291 | 0.021 | 0.028 | 0.0508 | 0.06 | 0.0322 | 0.048 | 0.058 | 0.0531 | 0.1248 | 0.0761 | 0.0746 |
| Cytoplasmic Foci | 0.0741 | 0.0376 | 0.0851 | 0.0065 | 0.03 | 0.0192 | 0.0888 | 0.046 | 0.0794 | 0.0408 | 0.0405 | 0.0354 | 0.1211 | 0.0664 | 0.1531 | 0.0206 | 0.0187 | 0.0207 |
| Eisosomes | 0.0009 | 0.0002 | 0.0003 | 0.0001 | 0.0003 | 0.0003 | 0.0009 | 0.0001 | 0.0001 | 0.0002 | 0.0003 | 0.0001 | 0.0005 | 0.0002 | 0.0002 | 0.0004 | 0.0003 | 0.0001 |
| Endoplasmic Reticulum | 0.0043 | 0.0004 | 0.001 | 0.0012 | 0.0074 | 0.0035 | 0.0028 | 0.0004 | 0.0017 | 0.0041 | 0.002 | 0.0007 | 0.0028 | 0.0007 | 0.0027 | 0.0023 | 0.0101 | 0.0004 |
| Endosome | 0.0103 | 0.0028 | 0.0141 | 0.0067 | 0.0418 | 0.0049 | 0.0227 | 0.0011 | 0.0104 | 0.0187 | 0.0484 | 0.0038 | 0.0137 | 0.0028 | 0.0153 | 0.0093 | 0.0656 | 0.0031 |
| Golgi | 0.0046 | 0.0004 | 0.0088 | 0.0006 | 0.0199 | 0.0035 | 0.005 | 0.0004 | 0.0035 | 0.0276 | 0.017 | 0.0014 | 0.0035 | 0.0005 | 0.0045 | 0.0058 | 0.0151 | 0.0005 |
| Lipid Particles | 0.0125 | 0.0053 | 0.0118 | 0.0038 | 0.0083 | 0.0063 | 0.0185 | 0.0031 | 0.0209 | 0.0424 | 0.0492 | 0.0054 | 0.0207 | 0.0049 | 0.0156 | 0.0163 | 0.0955 | 0.0016 |
| Mitochondria | 0.0032 | 0.0005 | 0.0057 | 0.0009 | 0.008 | 0.0059 | 0.0128 | 0.0067 | 0.0146 | 0.0074 | 0.0107 | 0.0041 | 0.0052 | 0.0006 | 0.0044 | 0.0038 | 0.0161 | 0.0002 |
| None | 0.7101 | 0.7212 | 0.34 | 0.5032 | 0.7801 | 0.7886 | 0.6316 | 0.7721 | 0.3479 | 0.3936 | 0.6089 | 0.8593 | 0.6179 | 0.7157 | 0.3353 | 0.5505 | 0.5675 | 0.8538 |
| Nuclear Periphery | 0.0077 | 0.0023 | 0.0042 | 0.0184 | 0.0141 | 0.0073 | 0.0094 | 0.0011 | 0.0056 | 0.0103 | 0.0057 | 0.0031 | 0.0169 | 0.0009 | 0.0061 | 0.01 | 0.0329 | 0.0021 |
| Nucleolus | 0.006 | 0.0118 | 0.0089 | 0.0081 | 0.0006 | 0.008 | 0.0044 | 0.0066 | 0.0075 | 0.0046 | 0.0029 | 0.0009 | 0.0046 | 0.0091 | 0.0067 | 0.0015 | 0.002 | 0.0002 |
| Nucleus | 0.0119 | 0.0549 | 0.088 | 0.2896 | 0.0024 | 0.025 | 0.0163 | 0.025 | 0.0636 | 0.1788 | 0.0035 | 0.006 | 0.0049 | 0.0235 | 0.0555 | 0.0823 | 0.0078 | 0.0011 |
| Peroxisomes | 0.0133 | 0.0035 | 0.0148 | 0.0008 | 0.0298 | 0.0065 | 0.0128 | 0.0055 | 0.0139 | 0.0322 | 0.026 | 0.0054 | 0.0209 | 0.0022 | 0.0115 | 0.0162 | 0.0357 | 0.0015 |
| Punctate Nuclear | 0.0582 | 0.1104 | 0.3417 | 0.1085 | 0.017 | 0.0512 | 0.0915 | 0.1004 | 0.3938 | 0.1246 | 0.0592 | 0.0372 | 0.0777 | 0.081 | 0.3159 | 0.0197 | 0.0105 | 0.0346 |
| Vacuole | 0.003 | 0.0011 | 0.0021 | 0.0008 | 0.0031 | 0.0019 | 0.0035 | 0.0005 | 0.0014 | 0.0011 | 0.0092 | 0.0003 | 0.0019 | 0.0023 | 0.0011 | 0.0017 | 0.0059 | 0.0001 |
| Vacuole Periphery | 0.0011 | 0.0001 | 0.0007 | 0.0004 | 0.0034 | 0.001 | 0.0016 | 0.0001 | 0.0005 | 0.0007 | 0.0041 | 0.0002 | 0.0009 | 0.0002 | 0.0004 | 0.0006 | 0.005 | 0.0001 |
Sequencing Data
| R1 | R2 | |||||||||
|---|---|---|---|---|---|---|---|---|---|---|
| G1 Post-START | S/G2 | Metaphase | Anaphase | Telophase | G1 Post-START | S/G2 | Metaphase | Anaphase | Telophase | |
| Gene Expression | 13.0691 | 20.5843 | 10.7334 | 7.576 | 16.1378 | 13.6838 | 18.1408 | 14.8065 | 7.7289 | 17.3043 |
| Translational Efficiency | 0.7841 | 0.6194 | 0.3822 | 0.5214 | 0.4615 | 0.556 | 0.461 | 0.4687 | 0.6224 | 0.4692 |
Hit Data
| Dataset | Hit |
|---|---|
| Protein Concentration | ✔ |
| Protein Localization | ✘ |
| Gene Expression | ✔ |
| Translational Efficiency | ✘ |
Endocytosis
| Temp | Actin Patch (Sac6-tdTomato) | Cortical Patch (Sla1-GFP) | Late Endosome (Snf7-GFP) | Vacuole (Vph1-GFP) |
|---|---|---|---|---|
| 37℃ | ||||
| RT |
Cell Cycle Omics
CYCLoPs (Sgo1-GFP)
| Gene / Allele | Actin Patch (Sac6-tdTomato) | Cortical Patch (Sla1-GFP) | Late Endosome (Snf7-GFP) | Vacuole (Sac6-tdTomato) |
|---|
| Gene | Images |
|---|
| Gene | Images |
|---|
Images are not yet available
Images are not yet available